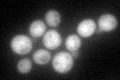
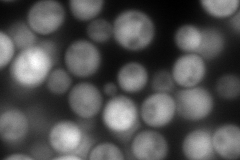
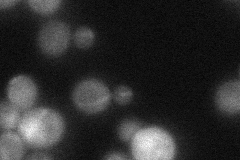
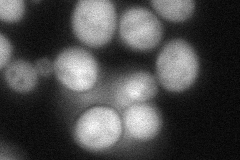

View description
6-phosphogluconolactonase, catalyzes the second step of the pentose phosphate pathway; weak multicopy suppressor of los1-1 mutation; homologous to Sol2p and Sol1p
Localization:
Intensity:
Fold change:
Significance:
-
C’ GFP library in SD
cytosol56.93 -
N' NOP1pr-GFP in SD

cytosol247.335 -
N' TEF2pr-mCherry in SD
cytosol360.076 -
N' NATIVEpr-GFP in SD
cytosol28.6791 -
N' TEF2pr-VC and Cyto-VN in SD
cytosol77.3717 -
C’ GFP library in SD+DTT

cytosol55.540.97No -
C’ GFP library in SD+H2O2

cytosol60.521.06No -
C’ GFP library in Starvation Media

cytosol67.351.18No -
C’ GFP library on the background of Pup2-DaMP

cytosol -
C’ GFP library on the background of CCT mutant

cytosol52.13430.915688No
